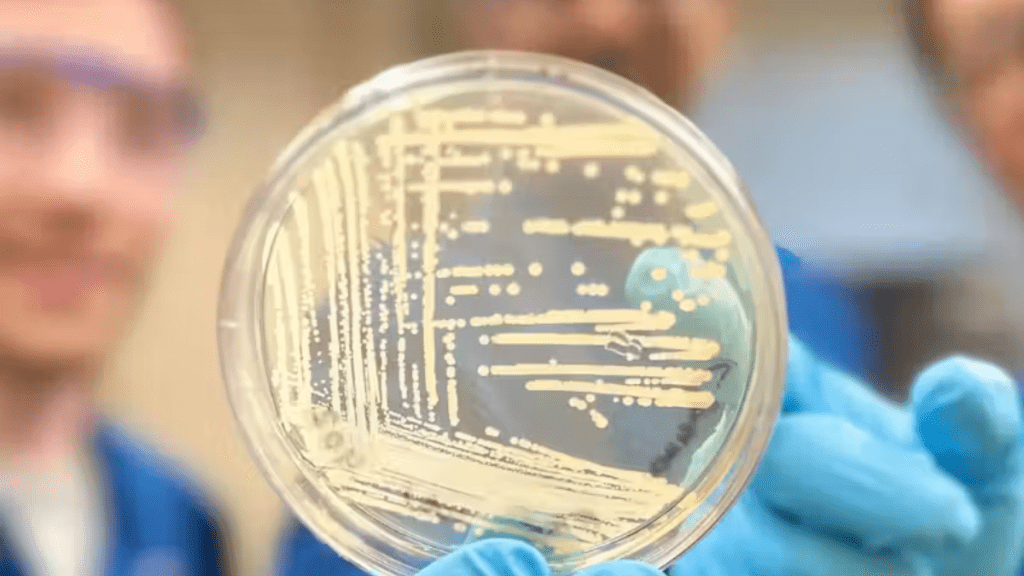

Novo composto pode matar superbactérias resistentes a antibióticos.
Um novo composto, que pode matar superbactérias resistentes a medicamentos, foi desenvolvido por pesquisadores de Harvard. Agora, o futuro de cirurgias, transplantes e até mesmo o tratamento contra o câncer ganham mais um reforço!
O composto sintético foi eficiente contra uma longa lista de cepas como Staphylococcus aureus e Pseudomonas aeruginosa. A molécula tem uma grande eficiência ao se ligar aos ribossomos bacterianos, que controlam a síntese de proteínas da bactéria, dizem os cientistas.
Com a interrupção da função ribossômica mais poderosa, foi possível impedir a resistência das superbactérias a alguns antibióticos. “… nossos resultados mostram uma atividade inibitória significativamente melhorada contra uma longa lista de cepas bacterianas patogênicas que matam mais de um milhão de pessoas todos os anos”, disse Andrew Myers, professor de Química e Biologia Química de Harvard.
Efetivo contra bactérias
Ao longo dos anos, as bactérias foram ficando resistentes a alguns antibióticos.
Foi para combater esse problema que a equipe liderada por Andrew Myers, desenvolveu o composto sintético chamado cresomicina.
“Embora ainda não saibamos se a cresomicina e medicamentos semelhantes são seguros e eficazes em humanos, os nossos resultados mostram uma atividade inibitória significativamente melhorada contra uma longa lista de estirpes bacterianas patogénicas”, explicou.
